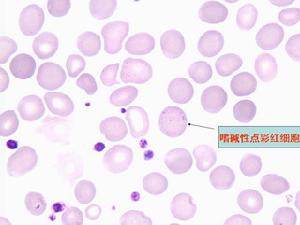
遺傳性橢圓形紅細胞增多症

疾病概述
 遺傳性橢圓形紅細胞增多症
遺傳性橢圓形紅細胞增多症遺傳性橢圓形細胞增多症是一種以外周血液中橢圓形細胞增多至25%以上為特點的遺傳性疾病。正常人的外周血液中亦可有少數橢圓形紅細胞,但至多不超過15%,而遺傳性橢圓形細胞增多症患者中這種細胞至少有25%,更多見的是超過75%,甚至多達90%。橢圓形紅細胞的橫徑和縱徑的比率不超過0.78。遺傳性橢圓形細胞增多症患者不全都有溶血現象,臨床上發生溶血性貧血者僅占10%~15%左右。
遺傳性橢圓形細胞增多症在世界各民族中均有發現。我國亦有少數病例報導。本病為遺傳性疾病,由常染色體顯性傳遞。男女均可得病。各家族間溶血的程度很不一致。在部分患者中,本病的基因與rh血型的基因位於同一染色體上。兩種基因不聯接時,則溶血較嚴重。
對本病的病因和發病機理目前尚不清楚。初步認為本病的缺陷也在紅細胞膜的支架蛋白。各病例的分子異常已發現有多種類型,所涉及的支架蛋白組成可以不同,所涉及的收縮蛋白的分子區域可以不同,膜蛋白缺失的量可以不等。這種異常細胞的破壞主要也是在脾臟內。
本病與遺傳性球形細胞增多症有相似之處,如細胞形態異常者在脾臟內破壞增多,胞膜中存在著某種通透性方面的缺陷促使三磷酸腺苷的利用加速。但致使紅細胞變成橢圓形的原因究竟是什麼,還有待科學家的進一步探討。
病理病因
 遺傳性橢圓形紅細胞增多症
遺傳性橢圓形紅細胞增多症引起本病膜缺陷的分子遺傳學異常有:膜收縮蛋白僅鏈基因異常(稱為僅HE突變)、膜收縮蛋白僅鏈低表達等位基因(稱為膜收縮蛋白B鏈基因異常、蛋白異常及血型糖蛋白C和D(D為C的變異型)缺乏。其中主要為膜收縮蛋白結構異常,少數為紅細胞膜的蛋白缺乏或蛋白與錨蛋白的結合缺陷。
疾病分類
 遺傳性橢圓形紅細胞增多症
遺傳性橢圓形紅細胞增多症遺傳性橢圓形紅細胞增多症可分遺傳性和獲得性,診斷主要依靠形態學。凡在外周血塗片中見到成熟紅細胞形狀呈卵圓形、橢圓形、棒形或臘腸形,其橫經與縱經之比25%,並有家族遺傳史者可診斷為遺傳性橢圓形紅細胞增多症。正常人的成熟紅細胞也可有少數(<5%)為橢圓形,最多不應超過15%。
臨床表現
 遺傳性橢圓形紅細胞增多症
遺傳性橢圓形紅細胞增多症外周血中橢圓形紅細胞超過25%,其臨床表現及血液學改變差異很大。
1無溶血(隱匿型):橢圓形紅細胞雖增多,但無溶血表現。
2輕度溶血(溶血代償型):紅細胞壽命比正常稍短,網織紅細胞輕度增高,結合珠蛋白低於正常,由於造血功能的代償,多不出現貧血。絕大多數病人屬於這一類型。嚴重的可在新生兒期出現高膽紅素血症,甚至需要換血治療。合併感染時可出現骨髓不增生危象,亦有合併膽石症的報導。
診斷依據
 遺傳性橢圓形紅細胞增多症
遺傳性橢圓形紅細胞增多症1.有黃疸、貧血、脾大,多為幼年發病,可有家族史;
2.過度疲勞或感染可誘發溶血危象;
3.除一般溶血性貧血化驗所見;可見血片中有球形或橢圓形紅細胞,數量可從1-2%到60-70%,多數在10%以上(正常人一般低於5%);
4.紅細胞滲透脆性增高;
5.酸化甘油溶解試驗陽性;
6.SDS-聚丙烯山胺凝膠電泳進行紅細胞膜蛋白分析,部分病例可發現膜骨架蛋白缺陷。
實驗檢查
 遺傳性橢圓形紅細胞增多症
遺傳性橢圓形紅細胞增多症貧血程度的變化殊異。紅細胞計數一般為300萬~400萬/μl;在再生障礙危象時可降至100萬/μl以下,血紅蛋白亦成比例地下降.由於紅細胞呈球樣,而平均紅細胞體積正常,紅細胞的平均直徑稍低於正常,因而紅細胞酷似小球形紅細胞,平均紅細胞血紅蛋白的濃度增高。網織紅細胞增多(達15%~30%)與白細胞增多均為常見。
紅細胞的滲透脆性呈特徵性增高。但輕症者若不先在37℃下無菌的去纖維蛋白血中孵育24小時,試驗結果可能正常,直接抗球蛋白試驗(庫姆試驗)陰性。紅細胞自溶現象增加,但加入葡萄糖後可被糾正。
治療預防
 遺傳性橢圓形紅細胞增多症
遺傳性橢圓形紅細胞增多症沒有貧血或僅有輕度貧血者,一般不需要治療。溶血嚴重的,做脾切除術可使血紅蛋白和網織紅細胞恢復或接近正常。但脾切除後紅細胞形態異常變得更為明顯。由於嬰幼兒HE中一部分可自行減輕或緩解,脾切除術應在3歲以後考慮,的確需切脾者最好也在5歲以後進行。無症狀或僅有輕度貧血對身體健康影響不大者不需治療。如有較明顯溶血性貧血的應做脾切除。脾切除後橢圓形紅細胞的特徵依然存在,但溶血可停止或減輕,血紅蛋白可恢復正常,又可防止長期慢性溶血導致的併發症,如膽石症等。
預後治療
 遺傳性橢圓形紅細胞增多症
遺傳性橢圓形紅細胞增多症脾切除是遺傳性球型或橢圓紅細胞增多症唯一的療法,適用於45歲以下嚴重持續性貧血(Hb<10g),黃疸或膽絞痛,或是發生再障危象(原紅細胞減少症)的病人。術前患者應接受肺炎球菌和嗜血性流感疫苗免疫。手術中發現伴有膽石或證明有病的膽囊應當切除。脾切除後症狀通常可緩解,紅細胞計數上升,網織紅細胞計數恢復正常。由於球形紅細胞增多症持續存在,紅細胞滲透脆性仍然增加,但這些異形紅細胞因無脾臟的作用在循環中生存時間較前延長,因而病情可得到改善。
手術方案
遺傳性橢圓形紅細胞增多症
遺傳性橢圓形紅細胞增多症1.對門靜脈高壓患者,術前應改善肝功能,糾正出血傾向。
2.對某些嚴重貧血者,應反覆多次輸血後,再行脾切除。
4.按普外科腹部手術前準備。
手術要點
 遺傳性橢圓形紅細胞增多症
遺傳性橢圓形紅細胞增多症1.手術可取左側肋緣下或上腹正中“L”形切口,術野顯露充分。
2.切睥前宜先結紮脾動脈。
3.脾切除後,脾窩應放置引流管。
4.血液病患者須將副脾一併切除。
5.切除脾臟時注意不要損傷胰尾部,以免術後發生胰瘺。
術後處理
 遺傳性橢圓形紅細胞增多症
遺傳性橢圓形紅細胞增多症1.按一般腹部手術後處理。
2.引流管一般於術後24~48h拔除。
3.術後每日查白細胞和血小板。術後當血小板超過(0.8~1)×1012/L時,應行抗凝治療。
療效評價
 遺傳性橢圓形紅細胞增多症
遺傳性橢圓形紅細胞增多症1.完全緩解:脾切除後貧血及溶血完全消失,血紅蛋白120g/L以上,網織紅細胞3%以下,經隨訪血象一直保持平穩;
2.部分緩解:脾切除後臨床及血象均較術前改善,但未達到完全緩解的標準;
3.無效:脾切除後症狀及血象均無改善;
4.復發:脾切除後有效,以後再次惡化。
本病系遺傳性疾病,無特殊根治療法。脾切除可減低脾臟對周圍血中異形紅細胞的清除作用。對術後效果不能期望太高,術前應向病人及其家庭交代清楚。另囑病人平時注意避免勞累和感染,以免引起急性溶血發作。
嬰兒治療
 遺傳性橢圓形紅細胞增多症
遺傳性橢圓形紅細胞增多症1.紅細胞形態外周血中橢圓形、卵圓形雪茄形或臘腸形成熟紅細胞增多。此種形態異常,在出生時可能不存在多於生後4~6個月開始出現。另外,在球形細胞性HE,尚有小球形紅細胞和小橢圓形細胞;在口形細胞性HE,有許多細胞膜僵硬的口形細胞細胞中央淺染區有棒狀結構將其分割。溶血嚴重時周圍血象中可出現球形細胞或紅細胞碎片網織紅細胞和有核紅細胞形態正常。
2.紅細胞脆性試驗普通型HE大多正常在球形細胞性HE和重型HE患兒則增高。孵育後的脆性試驗和自溶試驗輕度增高,加葡萄糖或ATP後可被糾正。
3.紅細胞自溶試驗在球形細胞性HE增高,加入葡萄糖或ATP僅部分糾正。各類型HE的紅細胞變形性均減低。51Cr標記紅細胞顯示壽命明顯縮短,多在脾臟內破壞。在HPP紅細胞對熱敏感(45~46℃即破碎正常紅細胞要49℃才破碎)。
臨床資料
 遺傳性橢圓形紅細胞增多症
遺傳性橢圓形紅細胞增多症患兒,男,7歲。因臉色蒼白4年,加劇4個月,於1997年4月8日入院。發病時無發熱及全身性出血傾向。既往體健,否認苯等化學物質及放射性核素接觸史,無服用細胞毒性藥物及氯黴素、磺胺藥、解熱鎮痛藥史。5個月前在當地查Hb70g/L,經抗貧血治療無明顯效果。查體:面色蒼白,全身淺表淋巴結未觸及,皮膚、鞏膜無黃染及瘀點、瘀斑,心率80次/分,無病理性雜音,腹平軟,肝、脾肋緣下未捫及,神經系統未發現異常。實驗室檢查:Hb50g/L,WBC2.9×109/L,BPC47×109/L,Ret0.005,多數成熟紅細胞呈橢圓形;尿膽紅素(-),尿膽原4.2μmol/L,天冬氨酸轉氨酶48IU/L(速率法);B超:肝正常,脾厚2.5cm,肋緣下0.5cm;骨髓象:增生減低,粒系占0.220,紅系占0.035,粒∶紅=6.3∶1,粒細胞形態未見明顯改變,大多數成熟紅細胞呈橢圓形,占0.780,淋巴細胞比例增高,以成熟淋巴細胞為主,形態大致正常,巨核細胞全片1個,血小板少見;細胞外鐵(+);骨髓小粒以非造血細胞為主;紅細胞脆性試驗、血紅蛋白電泳均未見異常。診斷:遺傳性橢圓形紅細胞增多症,再生障礙性貧血。其母外周血大多數紅細胞呈橢圓形;其父外周血成熟紅細胞形態大致正常。入院後給予康力龍、利血生、硝酸一葉秋鹼、皮質激素、胸腺肽等治療,外周血象改善,住院27天出院。出院時檢查WBC8.9×109/L,Hb70g/L,BPC49×109/L,Ret0.009。

